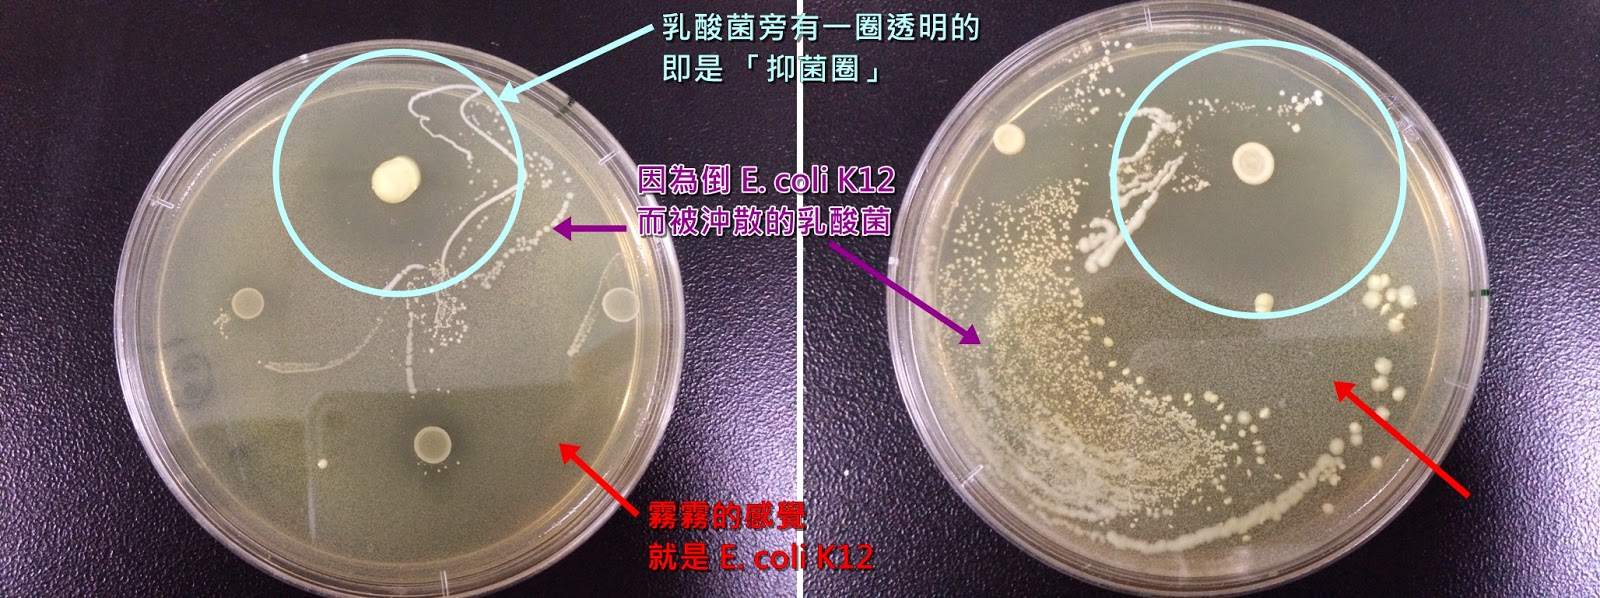
楊容的學習記錄: 0513抑菌實驗結果

菌片 實驗
Study the characteristics of 菌片 實驗 using our comprehensive set of substantial collections of learning images. providing valuable teaching resources for educators and students alike. making complex concepts accessible through visual learning. Browse our premium 菌片 實驗 gallery featuring professionally curated photographs. Excellent for educational materials, academic research, teaching resources, and learning activities All 菌片 實驗 images are available in high resolution with professional-grade quality, optimized for both digital and print applications, and include comprehensive metadata for easy organization and usage. Our 菌片 實驗 images support learning objectives across diverse educational environments. Advanced search capabilities make finding the perfect 菌片 實驗 image effortless and efficient. Cost-effective licensing makes professional 菌片 實驗 photography accessible to all budgets. The 菌片 實驗 archive serves professionals, educators, and creatives across diverse industries. Instant download capabilities enable immediate access to chosen 菌片 實驗 images. Time-saving browsing features help users locate ideal 菌片 實驗 images quickly. Professional licensing options accommodate both commercial and educational usage requirements. Our 菌片 實驗 database continuously expands with fresh, relevant content from skilled photographers. The 菌片 實驗 collection represents years of careful curation and professional standards. Whether for commercial projects or personal use, our 菌片 實驗 collection delivers consistent excellence. Each image in our 菌片 實驗 gallery undergoes rigorous quality assessment before inclusion. Comprehensive tagging systems facilitate quick discovery of relevant 菌片 實驗 content. Regular updates keep the 菌片 實驗 collection current with contemporary trends and styles.

![过氧化氢灭菌生物指示菌片[嗜热脂肪芽孢杆菌菌片][纸片(内含不锈钢条)]价格,详情介绍-960化工网 – 960化工网](https://scimg.chem960.com/usr/bio/0539640945522315253-14.jpg)































![為什麼微生物培養時要分離出單一菌落 [實驗] 微生物的接種與環境中的微生物 | 藥師家](https://i1.wp.com/1.bp.blogspot.com/-PNU_cknJvJE/WP9XNfVal1I/AAAAAAAATSM/2JGYVIOmJlMGzrZBPTxk5ww1Lry29AueACK4B/s1600/%25E6%259C%25AA%25E5%2591%25BD%25E5%2590%258D2.png)

































